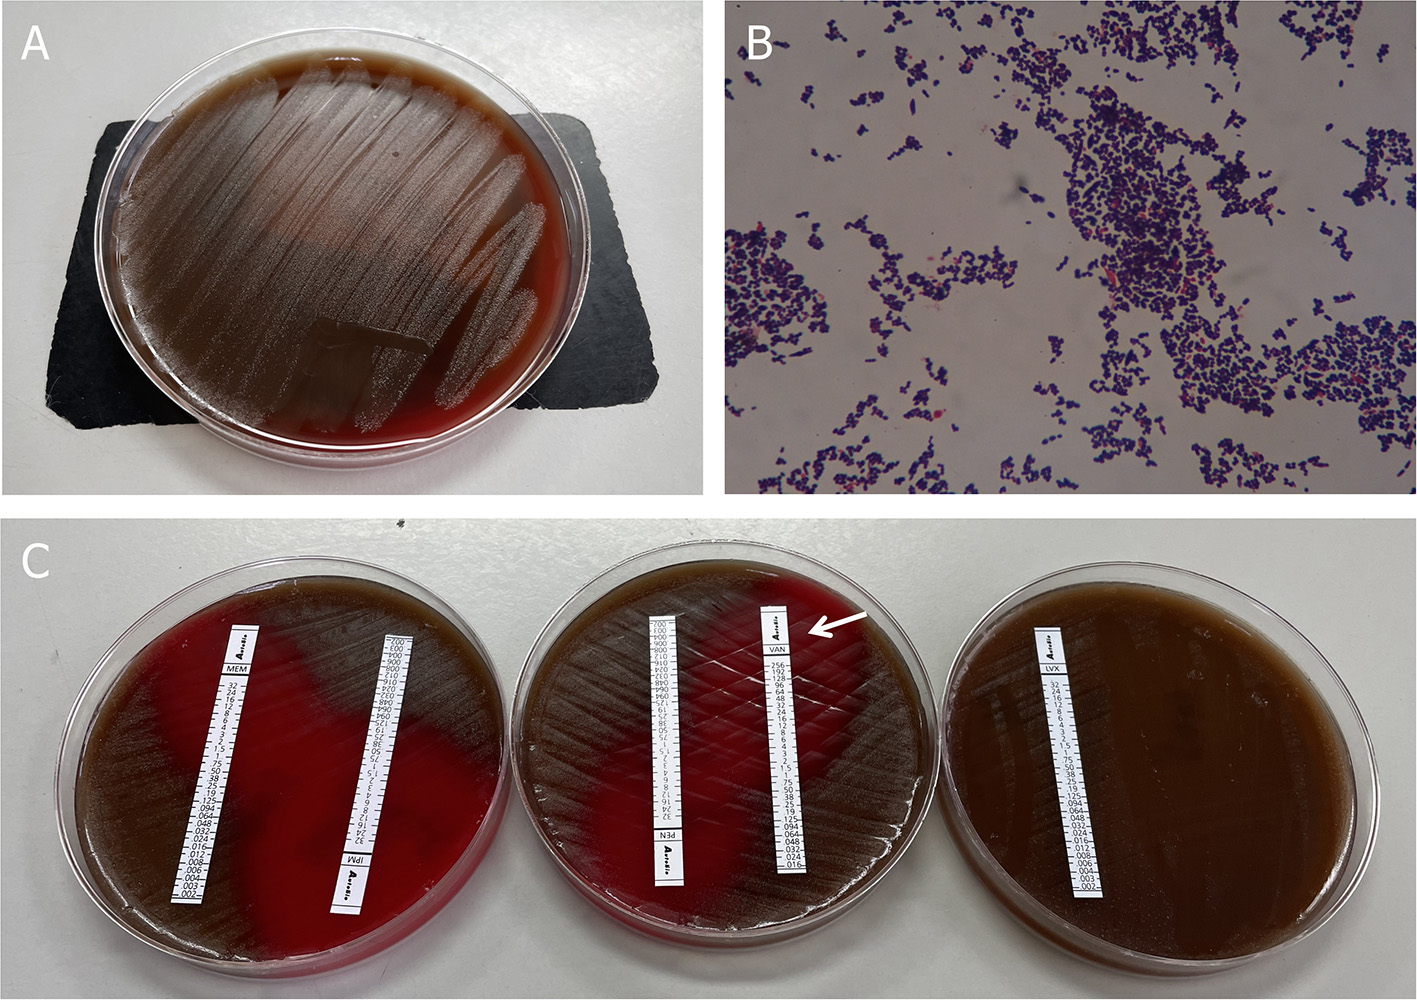

Abstract
Introduction:
Abiotrophia defectiva (A. defectiva) is a rare species leading to infective endocarditis (IE) with a poor prognosis. We describe a previously healthy patient with mitral valve infective endocarditis caused by A. defectiva.
Case report:
A young man was admitted with intermittent fever. Echocardiography confirmed vegetation on the mitral valve with evidence of valve perforation and severe mitral regurgitation. Three sets of blood cultures became positive for A. defectiva. As he presented with manifestations of mesenteric arterial branch pseudoaneurysm, splenic and renal infarction, mitral valve replacement, and embolization of superior mesenteric aneurysm were operated during 8 weeks' targeted antibiotic therapy.
Conclusion:
This case study emphasizes the importance of considering A. defectiva as a rare but important cause of IE and of performing blood culture to make its accurate diagnosis and timely anti-infective treatment. Early surgical management and active prevention of complications have been associated with a favorable prognosis.
Introduction
Abiotrophia defectiva (A. defectiva), once considered as a nutritionally variant Streptococci (NVS) and later moved to a new genus Abiotrophia, is a part of the normal flora of the oral cavity, gastrointestinal tract, and genitourinary system. Among a variety of severe invasive diseases caused by A. defectiva, IE is one of the most frequently reported infections. But, it is still rare for all the endocarditis, with a high rate of failure and complications in some reported cases. Thus far, a suitable treatment strategy remains to be explored.
Case Description
A 24-year-old male patient, without preexisting diseases, was admitted for 20 days of intermittent fever (up to 38.6°C), accompanied by headache and fatigue, but no chills, cough, sputum, abdominal pain, diarrhea, chest pain, or tightness. He denied a prior history of congenital heart disease, alcoholic drinking, cigarette smoking, and injection drug use. He had not recently undergone any sore throat, dental procedures, skin rash, or surgery. He had been prescribed a non-steroidal anti-inflammatory drug by his general practitioner but this provided no relief.
Before admission, the patient had been admitted to the respiratory department in the local hospital because of fever and the laboratory studies showed normal leukocytes but elevated C-reactive protein of 38.67 mg/l (normal range: 0–8 mg/l). A transthoracic echocardiogram (TTE) revealed vegetation on the anterior aspect of the mitral leaflet, measuring 1.3 × 0.7 cm. After following the treatment with intravenous amoxicillin (dosage unknown) only once during the emergency care for 1 day, the patient was then referred to our hospital and hospitalized for further examination and treatment.
On admission, with a presumptive diagnosis of IE, physical examination showed a grade 4/6 systolic murmur over the mitral area upon auscultation and obvious splenomegaly via palpation. No Janeway's lesions, Osler's nodes were observed. Laboratory studies revealed normocytic anemia (hemoglobin 10.8 g/dl, normal range: 13.0–17.5 g/dl), normal leukocytes but elevated C-reactive protein of 30.61 mg/l, and erythrocyte sedimentation rate of 38 mm in the first hour. TTE confirmed isolated vegetation of 2.24 cm2 on the anterior mitral valve leaflet, with valve perforation and severe mitral regurgitation (Figure 1).
Figure 1

Transthoracic echocardiogram. (A) Apical three-chamber view shows a 2.24 cm2 vegetation in the anterior leaflet of the mitral valve, (B) the size of the vegetation decreased to 1.91 cm2 on the 7th hospital day, (C) apical four-chamber view shows severe mitral regurgitation, and (D) short-axis parasternal view shows severe mitral regurgitation contrasted with color Doppler. LA, left atrium; LV, left ventricle.
Three sets of blood cultures were taken before the patient was commenced on empirical treatment with intravenous vancomycin (1 g every 12 h). After 31 h, his blood culture became positive for Gram-positive cocci, which was identified as Abiotrophia defectiva. Antimicrobial susceptibility testing revealed that it is susceptible to vancomycin, imipenem, and meropenem, but resistant to penicillin and levofloxacin. All outcomes of the three blood cultures presented the same bacteria—A. defectiva (Figure 2).
Figure 2
Blood culture results. (A) Growth of colonies of Abiotrophia defectiva in the blood agar. (B) Gram stain reveals Gram-positive pleomorphic coccobacilli, arranged in chains (original magnification, 1,000X). (C) Antimicrobial susceptibility testing demonstrated susceptibility to vancomycin, imipenem, and meropenem, but was resistant to penicillin and levofloxacin.
Three sets of blood cultures were taken before the patient was commenced on empirical treatment with intravenous vancomycin (1 g every 12 h). All three sets of blood cultures consist of one bacterial aerobic flask, one bacterial anaerobic flask, and one fungal culture flask. After 31 h, his blood culture became positive for Gram-positive cocci, which was identified as Abiotrophia defectiva (BACTEC FX400 Automatic Bacterial Cultivator). Within the next 1–2 days, all the flasks are positive for A. defectiva and mass spectrometry (VITEK MS) was used to identify its authenticity. Antimicrobial susceptibility testing (Epsilometer test, E-test) revealed it susceptible to vancomycin [minimum inhibitory concentration (MIC) 0.32 ug/ml; breakpoint 100%], imipenem, and meropenem, but resistant to penicillin and levofloxacin. The MICs are assessed according to criteria listed in CLSI M45 (Figure 2, Supplementary Data 1).
Until now, the patient met the modified Duke diagnostic criteria of IE, including two main criteria (positive blood cultures and evidence of endocardial involvement) (1).
While during the therapy, he developed progressively worsening abdominal pain with left upper quadrant tenderness to palpation. Contrast-enhanced abdomen CT demonstrated mesenteric arterial branch aneurysms and splenic and renal infarcts (Figure 3).
Figure 3

Complications of Abiotrophia defectiva infective endocarditis. (A) Mesenteric arterial branch aneurysms in abdomen CT. (B) Splenic infarction in abdomen CT. (C,D) Multiple renal infarction in abdomen CT.
Later on hospital day 10, in case of severe complications, the patient underwent mitral valve replacement under pump (Figure 4). Intraoperatively, vegetations to the anterior leaflet of the mitral valve were seen with valve perforation. The native valve was successfully replaced with a mechanical valve (Carbomedics Prosthetic Heart Valve 27#, Sorin Group Italia Srl, Italy). Though both the cultures of vegetation and the blood after the surgery were negative, anti-infective treatment was continued with vancomycin for a planned duration of 8 weeks. The patient was started on warfarin 1.5 mg once daily for his mechanical valve.
Figure 4

(A) Postoperative mitral valve specimen. (B) Mesenteric arterial branch aneurysms in abdomen CT. (C) Digital subtraction angiography (DSA) indicated pseudoaneurysms (arrow) at the mesenteric arterial branch. (D) Two detachable coils were used to embolize the pseudoaneurysm.
During postoperative anti-infective treatment, repeated CT clarified no significant changes of organs' infarction but remarkable enlargement of the pseudoaneurysm with the thickened wall of the mesenteric arterial branch. To prevent the rupture of the aneurysm, two detachable coils were used to embolize the branches of the artery via digital subtraction angiography on hospital day 50 (Figure 4). The patient was discharged in a very good condition after 8 weeks' targeted antibiotic therapy.
Until 6 month-following up after discharge, he is currently symptoms free. Repeat TTE showed normal inner diameter and function of his heart. Abdominal ultrasound also showed that the spleen returned to normal size, and the infarcts gradually improved. Even with a long-term oral warfarin anticoagulation therapy, he lived a relatively healthy life. The progress and decision-making of the case above are reflected in the timeline (Figure 5).
Figure 5

The timeline of the case.
Discussion
As a facultative anaerobic gram-positive coccus, A. defectiva is first described as an NVS in 1961 from a case of infectious endocarditis (2). NVS were named the genus Streptococcus in 1989 following the use of 16S ribosomal RNA gene sequencing (3) and A. defectiva was added to the new genus Abiotrophia in 1995. Since the others were reclassified into a new genus, only the A. defectiva remained in this genus in 2000 (4). It is a component of the normal flora of the respiratory, urogenital, and gastrointestinal tracts. However, under immunocompromised conditions, A. defectiva was reported to cause ocular infections, otitis and sinus infections, osteoarticular and prosthetic joint infections, cerebral abscesses, iatrogenic meningitis, and pancreatic abscesses. Among these, endocarditis is the most common disease caused by A. defectiva. In addition, Abiotrophia endocarditis occupies about 4.3–6% of all streptococcal endocarditis before transferring into a new genus (5), which is characterized by a slow and indolent course. Most cases are likely misdiagnosed as culture-negative endocarditis, leading to delayed treatment. Berge et al. compared the epidemiology for IE in several streptococcus-like bacteria (SLB) among 568 episodes of bacteremia, focusing on Abiotrophia, Aerococcus, Gemella, and Granulicatella. The incidence of bacteremia with the four SLB genera was 30 episodes/1,000,000 population per year. Abiotrophia had the highest propensity of IE (4 of 19, 21%) and A. defectiva was more likely to cause IE [odds ratio (OR) 7.5, 95% CI 2.2–25, P < 0.05] (6).
In the etiological analysis, we also compared previously reported cases related to A. defectiva. Most of them have underlying heart diseases, such as rheumatic heart disease (7), congenital heart disease (8, 9), or a history of intravenous injection (10). Complications such as embolism and valve perforation almost appeared in all cases, and even multiple valves can be involved (11). Cases denying past medical history are rare, from children or non-elderly people. In these cases, serious complications such as heart failure and embolism did not occur. Therefore, simple anti-infective therapy or elective surgery after anti-infective therapy is sufficient. On the other hand, our patient, despite denying the past medical history, developed complications such as organ embolism and aneurysm in the early stage of anti-infection. In contrast, his condition was more urgent.
The choice of antibiotics in the early stage is essential. According to the current ESC guideline-recommended antibiotic therapy, penicillin G, ceftriaxone, or vancomycin should be used for 6 weeks, combined with an aminoglycoside for at least the first 2 weeks (12). Almost all susceptibility studies have also reported that A. defectiva is susceptible to vancomycin (13, 14). In this case study, the patient had no symptoms at first other than fever. Empirical treatment with vancomycin seems feasible through body temperature control and the decline of infectious markers. This was later confirmed by antimicrobial susceptibility testing.
Surgery is essential in the treatment of IE and is required in approximately half of the cases with severe complications (15). To prevent systemic embolism and avoid cardiac dysfunction such as heart failure and valve structural damage, patients with severe valve disease and large vegetation should consider early surgery while receiving antibiotic treatment. Both the recommendations for timing of surgery in complicated left-sided infective endocarditis from guidelines of the American College of Cardiology/American Heart Association (ACC/AHA) in 2020 (16) and the European Society of Cardiology (ESC) in 2015 (12) pointed out that early or urgent surgery should be performed if one of the following items is present: persistent bacteremia or fever lasting 5 days after onset of appropriate antibiotic therapy, recurrent emboli, and persistent vegetations despite appropriate antibiotic therapy, left-sided valve IE who exhibit mobile vegetations 10 mm in length with or without clinical evidence of the embolic event. After discussions of multiple disciplines team including experts from cardiac surgery, cardiology, vascular surgery, and infectious diseases, our patient, with a vegetation size of >10 mm, suffered from splenic and renal infarction suggesting that he might have an early mitral valve replacement. At the same time, we communicated with the patient timely about his condition, surgical risks, and costs. He agreed with the valve replacement surgery, which is closely related to his relatively enlightened thinking mode and the positive attitude toward life.
Infectious aneurysms, easier to rupture and hemorrhage with the thin walls, result from septic arterial embolism to the intraluminal space or spread of infection through the intimal vessels. There is no definite management plan for pseudoaneurysm owing to IE. While among antibiotic treatment, endovascular intervention, and surgery, it depends on the occurrence of rupture, the location in the artery bed, and the clinical status of the patient, not only the size of aneurysms (17). For the patient in this case study, embolization therapy was exerted to achieve a less invasive possibility.
In this case study, the accurate and timely identification of A. defectiva is of great significance for clinical diagnosis and treatment. Early surgical management and active prevention of complications reduce as many adverse events as possible. By reporting this, we wish to share our uncommon experience and hope that it may be helpful in future cases.
Conclusion
This case study indicates that although Abiotrophia defectiva is a rare cause of infective endocarditis, it may lead to a higher risk of adverse events such as infarctions and aneurysms. Thus, timely detection of blood culture and early diagnosis of A. defectiva help to guide antibiotic therapy. Prompt imaging evaluation and surgical intervention should be scheduled to avoid late complications. A more systematic scientific study would be necessary to evaluate its characteristics in the future.
Funding
This case study was supported by the National Natural Science Foundation of China (Grant No. 82070357).
Publisher's Note
All claims expressed in this article are solely those of the authors and do not necessarily represent those of their affiliated organizations, or those of the publisher, the editors and the reviewers. Any product that may be evaluated in this article, or claim that may be made by its manufacturer, is not guaranteed or endorsed by the publisher.
Statements
Data availability statement
The original contributions presented in the study are included in the article/Supplementary Material, further inquiries can be directed to the corresponding authors.
Ethics statement
Written informed consent was obtained from the individual(s) for the publication of any potentially identifiable images or data included in this article.
Author contributions
JL, LZ, XG, DY, and HL provided clinical care for the patient. JL wrote the manuscript. YW, DY, and HL reviewed the manuscript. All the authors approved the final draft of the manuscript and have made an intellectual contribution for publication.
Conflict of interest
The authors declare that the research was conducted in the absence of any commercial or financial relationships that could be construed as a potential conflict of interest.
Supplementary material
The Supplementary Material for this article can be found online at: https://www.frontiersin.org/articles/10.3389/fmed.2022.780828/full#supplementary-material
References
1.
Li JS Sexton DJ Mick N Nettles R Fowler VG Jr Ryan T et al . Proposed modifications to the Duke criteria for the diagnosis of infective endocarditis. Clin Infect Dis. (2000) 30:633–8. 10.1086/313753
2.
Frenkel A Hirsch W . Spontaneous development of L forms of streptococci requiring secretions of other bacteria or sulphydryl compounds for normal growth. Nature. (1961) 191:728–30. 10.1038/191728a0
3.
Bouvet A Grimont F Grimont A . Streptococcus defectivus sp. nov., and Streptococcus adjacens sp. nov., nutritionally variant streptococci from human clinical specimens. Int J Syst Bacteriol. (1989) 39:290–4. 10.1099/00207713-39-3-290
4.
Téllez A Ambrosioni J Llopis J Pericàs JM Falces C Almela M et al . Hospital clínic infective endocarditis investigators. epidemiology, clinical features, and outcome of infective endocarditis due to abiotrophia species and granulicatella species: report of 76 cases, 2000-2015. Clin Infect Dis. (2018) 66:104–11. 10.1093/cid/cix752
5.
Brouqui P Raoult D . Endocarditis due to rare and fastidious bacteria. Clin Microbiol Rev. (2001) 14:177–207. 10.1128/CMR.14.1.177-207.2001
6.
Berge A Kronberg K Sunnerhagen T Nilson BHK Giske CG Rasmussen M . Risk for endocarditis in bacteremia with streptococcus-like bacteria: a retrospective population-based cohort study. Open Forum Infect Dis. (2019) 6:ofz437. 10.1093/ofid/ofz437
7.
Bozkurt I Coksevim M Cerik IB Gulel O Tanyel E Leblebicioglu H . Infective endocarditis with atypical clinical feature and relapse by Abiotrophia defectiva. J Saudi Heart Assoc. (2017) 29:136–8. 10.1016/j.jsha.2016.06.003
8.
Gupta P Agstam S Angrup A Manoj RK Kanaujia R Ray P . Infective endocarditis caused by Abiotrophia defectiva presenting as anterior mitral leaflet perforation mimicking cleft anterior mitral leaflet. J Family Med Prim Care. (2020) 9:1229–1231. 10.4103/jfmpc.jfmpc_1004_19
9.
Song SH Ahn B Choi EH Lee SP Cho EY Bae EJ et al . Abiotrophia defectiva as a cause of infective endocarditis with embolic complications in children. Infection48:783–90. (2020) 10.1007/s15010-020-01454-z
10.
Rudrappa M Kokatnur L . Infective endocarditis due to abiotrophia defectiva and its feared complications in an immunocompetent person: rare, but real. J Glob Infect Dis. (2017) 9:79–81. 10.4103/0974-777X.204693
11.
Planinc M Kutlesa M Barsic B Rudez I . Quadruple-valve infective endocarditis caused by Abiotrophia defectiva. Interact Cardiovasc Thorac Surg. (2017) 25:998–9. 10.1093/icvts/ivx200
12.
Habib G Lancellotti P Antunes MJ Bongiorni MG Casalta JP Del Zotti F et al . ESC Guidelines for the management of infective endocarditis: the task force for the management of infective endocarditis of the European Society of cardiology (esc). endorsed by: European Association for cardio-thoracic surgery (eacts), the European association of nuclear medicine (EANM). Eur Heart J. (2015) 36:3075–128. 10.1093/eurheartj/ehv319
13.
Alberti MO Hindler JA Humphries RM . Antimicrobial susceptibilities of abiotrophia defectiva, granulicatella adiacens, and granulicatella elegans published correction appears in antimicrob agents chemother. Antimicrob Agents Chemother. (2015). 60:1411–20. 10.1128/AAC.02645-15
14.
Ratcliffe P Fang H Thidholm E Boräng S Westling K Özenci V . Comparison of MALDI-TOF MS and VITEK 2 system for laboratory diagnosis of Granulicatella and Abiotrophia species causing invasive infections. Diagn Microbiol Infect Dis. (2013) 77:216–9. 10.1016/j.diagmicrobio.2013.07.008
15.
Tornos P Iung B Permanyer-Miralda G Baron G Delahaye F Gohlke-Bärwolf Ch et al . Infective endocarditis in Europe: lessons from the Euro heart survey. Heart. (2005) 91:571–5. 10.1136/hrt.2003.032128
16.
Otto CM Nishimura RA Bonow RO Carabello BA Erwin JP Gentile F et al . ACC/AHA guideline for the management of patients with valvular heart disease: a report of the American College of Cardiology/American Heart association joint committee on clinical practice guidelines published correction appears in circulation. Circulation. (2021). 143:e72–227. 10.1161/CIR.0000000000000923
17.
Peters PJ Harrison T Lennox JL . A dangerous dilemma: management of infectious intracranial aneurysms complicating endocarditis. Lancet Infect Dis. (2006) 6:742–48. 10.1016/S1473-3099(06)70631-4
Summary
Keywords
Abiotrophia defectiva , infective endocarditis, mitral valve replacement, pseudoaneurysm, case report
Citation
Li J, Zhou L, Gong X, Wang Y, Yao D and Li H (2022) Abiotrophia Defectiva as a Rare Cause of Mitral Valve Infective Endocarditis With Mesenteric Arterial Branch Pseudoaneurysm, Splenic Infarction, and Renal Infarction: A Case Report. Front. Med. 9:780828. doi: 10.3389/fmed.2022.780828
Received
05 November 2021
Accepted
11 February 2022
Published
11 March 2022
Volume
9 - 2022
Edited by
Monica Catarina Botelho, Instituto Nacional de Saúde Doutor Ricardo Jorge (INSA), Portugal
Reviewed by
Torgny Sunnerhagen, Lund University, Sweden; Shijun Xia, Capital Medical University, China
Updates
Copyright
© 2022 Li, Zhou, Gong, Wang, Yao and Li.
This is an open-access article distributed under the terms of the Creative Commons Attribution License (CC BY). The use, distribution or reproduction in other forums is permitted, provided the original author(s) and the copyright owner(s) are credited and that the original publication in this journal is cited, in accordance with accepted academic practice. No use, distribution or reproduction is permitted which does not comply with these terms.
*Correspondence: Daokuo Yao yaodaokuo@126.comHongwei Li lhw19656@sina.com
This article was submitted to Infectious Diseases – Surveillance, Prevention and Treatment, a section of the journal Frontiers in Medicine
Disclaimer
All claims expressed in this article are solely those of the authors and do not necessarily represent those of their affiliated organizations, or those of the publisher, the editors and the reviewers. Any product that may be evaluated in this article or claim that may be made by its manufacturer is not guaranteed or endorsed by the publisher.